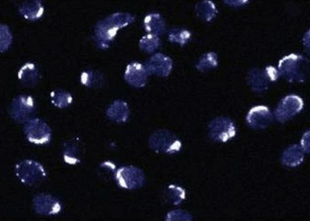
Anti-Bcl-2 (Ab-2) Rabbit pAb

Anti-Bcl-2 (Ab-2) Rabbit pAb
Anti-Bcl-2 (Ab-2) Rabbit pAb
询价
100ul
起订
上海 更新日期:2026-04-05
产品详情:
- 英文名称:
- Anti-Bcl-2 (Ab-2) Rabbit pAb
- 产品类别:
- 抗体
- 货号:
- PC68-100UG
公司简介
上海子起生物科技有限公司是一家集贸易、科研、服务于一体的高科技企业,专业致力于化学分析、食品、环境、化工、生命科学领域内的高品质分析、验证标准品、对照品、特种高分子材料、实验室设备和耗材等科研用品的集成供应商。
公司有一批具有资深行业背景和丰富市场经验的专业人士组成,主要为企事业单位、科研机构、新产品研发和生产企业等提供高品质化学品、仪器和耗材等;产品主要应用在食品、新产品研、 精细化工、新能源、新材料、环境化学、现代农业、生物工程、生物化学等诸多领域。
上海子起生物科技有限公司以完善和全面的产品线和专业的工作团队、贴心的服务、优质的产品、合理的价格以及顾问式的服务理念得到了众多客户的信任和一贯支持,并建立起中长期的合作关系。
我们一直众多国际知名化学产品、化工中间体、检测机构保持良好而及时的沟通,建立了战略合作关系。积极将国际一流产品和技术引入国内,为国内客户以作工具和技术交流。
| 成立日期 | (12年) |
| 注册资本 | 50万人民币 |
| 员工人数 | 10-50人 |
| 年营业额 | ¥ 100万-300万 |
| 经营模式 | 试剂,服务 |
| 主营行业 | 生物化工 |
Anti-Bcl-2 (Ab-2) Rabbit pAb相关厂家报价 更多
-

- Anti-Bcl-2 (Ab-2) Rabbit pAb
- 上海意杰生物科技有限公司
- 2026-04-05
- 询价
-

- ADC连接子多肽Mc-Val-Ala-PAB/1870916-87-2/Mc-Val-Ala-PAB
- 南京肽研生物科技有限公司 VIP
- 2026-04-05
- ¥1000
-

- Anti-PTRH2:Bcl-2转录抑制因子1抗体
- 上海冠导生物工程有限公司 VIP
- 2026-04-05
- 询价
-
- ANTI-MMP-2 (AB-8) MOUSE MAB (VB3)
- 北京智杰方远科技有限公司
- 2026-04-05
- ¥4066